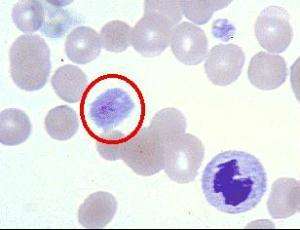
淋巴结肿大8个成因,脖子淋巴结肿大图片

引发淋巴结肿大原因可以归纳为8种。因为淋巴结发生炎症,毒性或细菌侵入淋巴结肿大,伴有疼痛感,手可以触及。淋巴结是人体免疫、增殖、过滤场所,更是接受抗原刺激产生免疫应答反应的位置,它能够及时收到外来致病因素信号,并产生抗体消灭来犯病菌。

1、恶性淋巴瘤
以长期低热、周期性发热,不明原因的进行性淋巴结肿大,应考虑恶性淋巴瘤。

2、HIV急性感染期
全身淋巴结肿大、发热、咽痛、皮疹、肌关节痛、头痛等类似流感症状,处于HIV急性感染期多见。

3、颈部转移瘤
周围组织粘连、质地坚硬、生长速度快、肿块固定的特征,颈部淋巴结肿大常发生在肿瘤转移和感染时出现。
4、慢性白血病
皮肤瘙痒或紫癜、骨痛、低热、气短心悸、头晕、盗汗、乏力等早期症状,白血病引发的淋巴结肿大一般为全身性,以腹股沟、腋下、颈部可见,伴有血液、骨髓出现大量幼稚细胞。

5、淋巴结核
临床观察发现,淋巴结核和淋巴瘤辨别存在一定难度,有些会出现破溃有些不会,特征就是淋巴结肿大。

6、淋巴结转移
多发在食管癌和胃癌,可以触摸到锁骨上出现小淋巴结肿大,固定、坚硬、无压痛感。

7、细菌感染
以急性炎症表现引起的下颌淋巴结肿大,较容易区分肿大的淋巴结活动度良好、质地较软,随着炎症缓解和消失,下颌淋巴结肿大会自行恢复。

8、病毒感染
包括传染性单核细胞增多症、麻疹等也可以引发淋巴结肿大。
番茄医生提醒,通过以上8种病因可以了解,当病毒感染和细菌感染,通常随着炎症和原发病好转,肿大可自行恢复或消失。应重视恶性肿瘤引起的淋巴结肿大,要及时跟踪处理好原发的肿瘤。当然,多数的淋巴结肿大是炎症引起,所以不必恐惧淋巴结肿大,它本身恶变率较低,只要找到病因及时治疗即可。